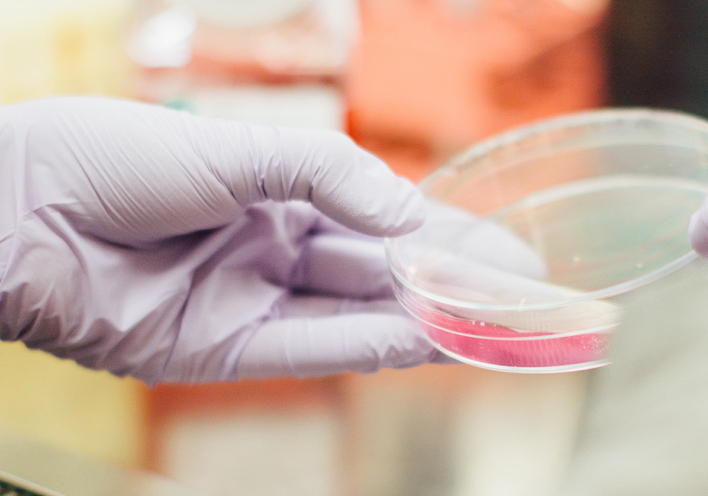
Η MSD στη μάχη κατά του Covid-19

Ο υπουργός Υγείας γράφει για τη μάχη που δώσαμε και εκφράζει την αισιοδοξία του για την επόμενη μέρα


Αυτό το καλοκαίρι δεν επικεντρώνεται στις διακοπές αλλά στην υγεία μας
Ένας νέος ιός, ο κορωνοϊός Sars-Cov2, άλλαξε μέσα σε σύντομο χρονικό διάστημα την καθημερινότητα των ανθρώπων σε όλο τον πλανήτη: έφερε μια νέα ασθένεια, τον Covid-19, που ήδη έχει σκοτώσει εκατοντάδες χιλιάδες ανθρώπους παγκοσμίως. Η ιατρική κοινότητα έχει επικεντρωθεί στην προσπάθεια να βρεθεί αποτελεσματική θεραπεία για τη νόσο, καθώς και εμβόλιο που να προστατεύει από τον ιό. Έναν ιό, η εξάπλωση του οποίου είχε ολέθρια αποτελέσματα σε πολλούς κατοίκους του πλανήτη λόγω και των κοινωνικοοικονομικών επιπτώσεων που έχει επιφέρει. Βιώσαμε πρωτόγνωρες καταστάσεις, για κάποιους ιδιαίτερα οδυνηρές. Μέσα σε κλίμα αβεβαιότητας η ζωή μας προσπαθεί να ξαναβρεί τους ρυθμούς της, «τραυματισμένη» από μία πανδημία που κανείς ακόμη δεν ξέρει πώς και πότε θα λήξει. Ήρθε ένα καλοκαίρι διαφορετικό, που φέτος δεν επικεντρώνεται στις διακοπές αλλά στην υγεία μας. Ας διατηρήσουμε, όμως, την αισιοδοξία μας αυτή την τόσο λαμπερή εποχή του χρόνου, ελπίζοντας ότι σύντομα και αυτή η «απειλή» θα αποτελεί παρελθόν, όπως και τόσες άλλες ασθένειες που νίκησε η επιστήμη.
Επιμέλεια αφιερώματος: Σοφία Νέτα, Κατερίνα Κοντοσταυλάκη
Εικονογράφηση: Γιώργος «Mambo», Instagram: mamboathens
Ο υπουργός Υγείας γράφει για τη μάχη που δώσαμε και εκφράζει την αισιοδοξία του για την επόμενη μέρα
«Ίσως αυτή η κρίση να ήταν μια "ευλογία" για την ανθρωπότητα παρόλες τις παραπάνω απώλειες»
«Oι πρώτοι ασθενείς που νοσηλεύτηκαν είχαν σοβαρές διαταραχές στην πήξη του αίματος»
«Η κοινωνία μας, δρώντας συλλογικά, πρέπει να μετριάσει την απειλή»
«Η πίεση για θεραπεία και προφύλαξη δεν πρέπει να θέσει σε κίνδυνο την ασφάλεια και αποτελεσματικότητα των μελλοντικών φαρμάκων και εμβολίων»
Σε ποιο στάδιο βρίσκεται η πανδημία του κορωνοϊού στη χώρα μας;
Ποιο είναι το μέλλον της δημόσιας υγείας;
Ένας από τους μεγαλύτερους Έλληνες ψυχιάτρους μιλά για την ενδοοικογενειακή βία και την καλή πλευρά ενός αρνητικού συναισθήματος.
«Σε εξαιρετικά δύσκολες συνθήκες αυτό που σώζει τελικά είναι ένα Δημόσιο Σύστημα παροχής ισότιμων υπηρεσιών υγείας»
Το θέμα είναι να φαίνεσαι όλο τον χρόνο τόσο λαμπερή όσο το καλοκαίρι, με μερικά απλά βήματα
Όποιο τύπο κουνουπιών κι αν ελκύεις, να ξέρεις πως η φύση έχει τον τρόπο να σε απαλλάξει από αυτά
Χρήσιμες συμβουλές από τον Δερματολόγο-Αφροδισιολόγο, Μαλάνο Δημήτριο
Οι ασθενείς οι οποίοι έχουν διάγνωση πολλαπλής σκλήρυνσης θα πρέπει να ξεκινούν άμεσα αγωγή με φάρμακα που λέγονται νοσοτροποποιητικά
Μερικές συμβουλές από τον χειρουργό-οφθαλμίατρο Δρ. Αναστάσιο-Ι. Κανελλόπουλο
Με το κύρος του Hellenic Healthcare Group
Tα οφθαλμολογικά σκευάσματα Artelac Ectoin & Artelac Complete, προσφέρουν ενυδάτωση μακράς διάρκειας
Η καμπάνια «Κόκκινη Κλωστή» αποτελεί έκφραση του Liberate Life, του οράματος της Sobi™ για τη βελτίωση της ποιότητας ζωής των ασθενών
Αξία για τον άνθρωπο, ευθύνη για την κοινωνία!
Ο Δερματολόγος-Αφροδισιολόγος Μάρκος Μιχελάκης δίνει συμβουλές για να προστατεύσουμε τα μαλλιά μας το καλοκαίρι
Όσον αφορά την αποτελεσματικότητα και τη μακροχρόνια ασφάλεια
Χρήσιμες συμβουλές προφύλαξης από την Δρ. Ανατολή Παταρίδου
Οι ταινίες μέτρησης Contour Next επιτυγχάνουν εξαιρετικά υψηλή ακρίβεια
Η πρόσβαση των ασθενών σε θεραπείες διευρύνεται, σημαντική παραμένει η ενημέρωση για τη λήψη εξατομικευμένης θεραπείας
Συμβάλλοντας στην προστασία της Δημόσιας Υγείας από τη μετάδοση της νόσου Covid– 19, πραγματοποιεί το σύνολο των τεστ ανίχνευσης
Ανοικτή συνεργασία στην έρευνα κατά του Covid-19, καινοτομία και παραγωγή με σεβασμό στον ασθενή
Οι δωρεές, η επάρκεια φαρμάκων και η ασφάλεια για τους εργαζόμενους
«Ο μεγαλύτερος κίνδυνος από τα εμβόλια σήμερα είναι ο μη εμβολιασμός»
Εκτός από τα άλλα πλεονεκτήματα που έχει, έχει και λιγότερη ακτινοβολία
«Η Takeda ρίχνει το βάρος της στην Έρευνα και την Ανάπτυξη, με στόχο η θεραπεία να είναι διαθέσιμη και προσβάσιμη για κάθε ασθενή που έχει ανάγκη»
Η επιστημονική ομάδα της Οδοντιατρικής Κλινικής iDentical αναλύει το σοβαρό πρόβλημα της οδοντικής φθοράς και τη σχέση της με τη γενική υγεία
Η νέα θεραπεία με το luspatercept-aamt θα προφέρει μια πολλά υποσχόμενη επιλογή
Cocktails δίπλα στο κύμα, μυστικοί κήποι και θερινά σινεμά 7 ορόφους πάνω από το έδαφος
Εστιατόρια, μπαρ και οι ταβέρνες που αγαπάμε
Γίνεται αθηναϊκό καλοκαίρι χωρίς ένα χωνάκι παγωτό στο χέρι;
Όσα δεν λείπουν από τις αποδράσεις της σεζόν, είτε φεύγεις για νησί είτε μένεις στην πόλη
Το μεγάλο αφιέρωμα της ATHENS VOICE με αφορμή την Παγκόσμια Ημέρα Περιβάλλοντος (5 Ιουνίου)
Με αφορμή τα 1000 τεύχη της ATHENS VOICE καταγράφουμε όλα όσα κάνουν αυτή την πόλη δική μας.